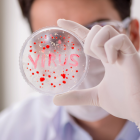
Nueve macacos adultos fueron infectados con el virus SARS-CoV-2.

Coronavirus: monos roban muestras de sangre tomadas para detectar COVID-19 en India
Las tres personas cuyas muestras de sangre fueron robadas por los primates fueron sometidas a nuevas pruebas

Referencial. Aunque se ha detectado coronavirus en algunos animales, no se ha demostrado que estos trasmitan el virus a seres humanos.
Unos monos se lanzaron sobre un empleado de un hospital cerca de Nueva Delhi, en India y se apoderaron de muestras de pruebas serológicas para COVID-19, lo que provocó el temor de que los primates contribuyan a propagar el nuevo coronavirus.

Ciencia y Tecnología
Coronavirus: Tailandia empieza ensayos con monos en busca de una vacuna
Gilson Pinargote
Los monos se llevaron tres muestras esta semana en Meerut, cerca de Nueva Delhi, antes de huir y trepar a los árboles cercanos. Uno de ellos masticó su botín.
Pero las otras dos muestras, descubiertas más tarde, no fueron dañadas, dijo el viernes a la AFP el director de la Facultad de Medicina de Meerut, Dheeraj Raj, después de que las imágenes del hurto se convirtieron en virales en las redes sociales.
In a shocking incident, a monkey snatched blood samples of Covid-19 patients being taken to the LLRM lab. Inquiry set up & the lab technician has been asked to give written explanation about why did he continue to make a video instead of asking for help.#Meerut #Coronavirus pic.twitter.com/N2bCeO2QA2
— Ishita Bhatia (@IshitaBhatiaTOI) May 29, 2020
“Todavía estaban intactas y no creemos que haya riesgo de contaminación o propagación”, precisó Raj.
Las tres personas cuyas muestras de sangre fueron robadas por los monos fueron sometidas a nuevas pruebas. Si bien ya se ha detectado el nuevo coronavirus en animales, no se ha confirmado el riesgo de transmisión del animal a los seres humanos.
Las autoridades indias se enfrentan constantemente al problema de los monos ladrones, que roban alimentos o incluso teléfonos inteligentes. En muchas zonas rurales, los agricultores, cuyas cosechas son saqueadas por bandas de monos, han pedido la intervención de las autoridades locales para controlar su población.
Las autoridades municipales de Nueva Delhi recurrieron a los monos de cola larga para enfrentarse y repeler a otros simios más pequeños de los alrededores.
En India se registraron 175 nuevas muertes debidas al COVID-19 en 24 horas, con lo que el número total de víctimas, el viernes, alcanzó 4.706, según las cifras oficiales. El país, que ha sido muy vulnerable a la propagación del nuevo coronavirus, con sus megalópolis superpobladas y su deficiente sistema de salud, ha registrado un número récord de nuevos casos en los últimos días.